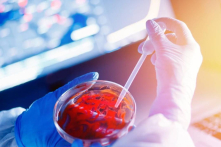
Chuyên gia cảnh báo: Úc đề phòng sự bùng phát trở lại của ‘Cái chết đen’

Hiểu về HMPV – Nguy cơ và cách phòng ngừa
Sau đại dịch COVID-19, HMPV, hiện đang lây lan ở Trung Quốc, đã thu hút đáng kể một lượng quan tâm.

Trí tuệ nhân tạo có thể giúp tăng tỷ lệ IVF thành công
Làm IVF thất bại là một nỗi đau lớn đối với các gia đình hiếm muộn. Công nghệ AI mới có thể giúp tối ưu hóa số lượng trứng được lấy ra và cải thiện…

FDA hạn chế Nicotine trong thuốc lá và các sản phẩm thuốc lá khác
Cơ quan Quản lý Thực phẩm và Dược phẩm Hoa Kỳ (FDA) đã đưa ra kế hoạch hạn chế mức nicotine để làm mất tác dụng gây nghiện của các loại thuốc lá.

Đồ uống lạnh ảnh hưởng đến cơ thể như thế nào?
Một số người thắc mắc rằng, những đánh giá tiêu cực về nước đá dường như chỉ xuất hiện trong văn hóa của người Hoa.

Sự oán giận: Vị khách không lành mạnh trong trái tim
Loại thuốc nào an toàn, hiệu quả, miễn phí và chỉ cần một sự thay đổi tinh tế trong góc nhìn để phát huy tác dụng?

Nghiên cứu: Sử dụng mạng xã hội liên quan đến mức độ cáu kỉnh gia tăng ở người lớn
Những người dành phần lớn thời gian trong ngày với mạng xã hội có mức độ cáu kỉnh cao hơn đáng kể so với những người không sử dụng.

Chế độ ăn uống và sức khỏe đường ruột có thể ảnh hưởng đến bệnh viêm khớp dạng thấp
Hàng triệu người trên toàn cầu đang phải vật lộn với các triệu chứng suy nhược của bệnh viêm khớp dạng thấp.

Vì sao con người sợ bóng tối?
Nỗi sợ bóng tối không chỉ là phản ứng tự nhiên mà còn phản ánh những cảm giác bất an và mất kiểm soát trước môi trường xung quanh.
Chuyên gia cảnh báo: Úc đề phòng sự bùng phát trở lại của ‘Cái chết đen’
Cái Chết Đen, còn được gọi là bệnh dịch hạch chuột, đã từng lan rộng nhanh chóng ở châu Âu vào thế kỷ 14.

Uống 2 ly rượu mỗi ngày làm tăng nguy cơ mắc 7 loại ung thư
Mới đây, Tổng Y sĩ Hoa Kỳ Vivek Murthy đã cảnh báo rằng rằng uống hai ly đồ uống có cồn mỗi ngày có khả năng làm tăng nguy cơ mắc bảy loại ung thư…

Mỹ: Nhiều trẻ sơ sinh nằm ngủ ở tư thế dễ gây đột tử
Trong suốt nhiều thập kỷ, các chuyên gia sức khỏe đã nhấn mạnh rằng các bậc phụ huynh nên cho con nhỏ nằm ngửa khi ngủ để đảm bảo an toàn.

Sóng não bị gián đoạn gây tổn hại đến sức khỏe tâm thần và cách khắc phục
"Nếu bạn muốn chữa lành đầu gối bị vỡ, vậy tại sao lại không muốn sửa chữa bộ não bị rối loạn hoặc tần số sóng não bị gián đoạn?"

Tại sao con người lại ho? Có 2 loại bất thường có thể là dấu hiệu sớm của ung thư phổi
Mùa đông lạnh giá là thời điểm bùng phát các bệnh về đường hô hấp như viêm phế quản, viêm phổi, cảm cúm thông thường…

WHO: Nhiễm trùng hô hấp cấp tính đang gia tăng ở nhiều quốc gia phía Bắc
Theo Tổ chức Y tế Thế giới (WHO), một đợt bùng phát các ca bệnh về đường hô hấp đã được báo cáo ở một số quốc gia trên toàn thế giới.

3 bài tập giúp ổn định lượng đường trong máu và tăng cường sức mạnh cho đôi chân
Kiểm soát lượng đường trong máu là một vấn đề suốt đời đối với hầu hết bệnh nhân tiểu đường.

Cha mẹ hút thuốc làm tăng nguy cơ mắc đa xơ cứng ở trẻ em
Mới đây, một nghiên cứu đã cho thấy: Đối với trẻ em có khuynh hướng mắc bệnh đa xơ cứng (MS) di truyền, việc tiếp xúc với khói thuốc lá trong gia đình có thể…

43% bệnh nhân lao “ẩn mình” trong cộng đồng
"Khoảng 43% bệnh nhân lao trong cộng đồng chưa được phát hiện và điều trị hoặc được phát hiện/điều trị nhưng chưa báo cáo", theo TS.BSCC Đinh Văn Lượng, Giám đốc Bệnh viện Phổi Trung…

Chơi thể thao đồng đội giúp cải thiện chức năng điều hành ở trẻ em
Mới đây, một nghiên cứu đã phát hiện ra rằng chơi các môn thể thao đồng đội trong thời thơ ấu có thể giúp trẻ em rèn luyện trí não.

Nghiên cứu: trà và cà phê có thể giúp chống lại ung thư
Mới đây, một đánh giá trên tạp chí Cancer đã cho thấy việc uống cà phê và trà có thể giúp làm giảm nguy cơ mắc bệnh ung thư miệng, họng, đầu và cổ.

Bệnh nướu răng và bệnh tiểu đường: Mối liên hệ nghiêm trọng ít ai biết
Mối liên hệ chặt chẽ giữa bệnh nha chu (nướu) và bệnh tiểu đường có thể tàn phá nghiêm trọng sức khỏe của chúng ta.




















![[VIDEO] Người xưa dạy con: Muốn làm quan trước tiên phải làm người tốt](https://dev123.trithucvn2.net/wp-content/uploads/2026/04/muon-lam-quan-lam-nguoi-tot-160x106.png)